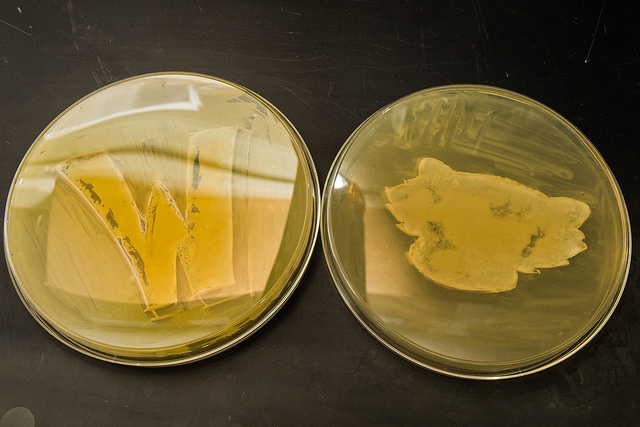

Bucky Badger visits Hittinger lab to meet his namesake yeast

Buckingham Badger stopped by Chris Hittinger’s genetics lab last week to meet Blastobotrys buckinghamii, a newly discovered strain of wild yeast that was named after him.

Bucky’s visit, which included lots of photos with Hittinger, members of the Hittinger lab and Dean Kate, was part of a lab-wide celebration in honor of the discovery. The yeast was found in the soil of Michigan’s Upper Peninsula by undergraduate Kayla Sylvester as part of her undergraduate research project for the lab.
“It was the most aggressive of the eight new species we found, and we thought it was appropriate to name it for Bucky Badger, as it reminded us of Bucky charging down the field,” says Hittinger.
Blastobotrys buckinghamii is one of approximately 1,500 known species of yeast. Cindy Van Matre, trademark licensing director at UW-Madison, believes that Blastobotrys buckinghamii is the first organism to be named in Bucky’s honor.